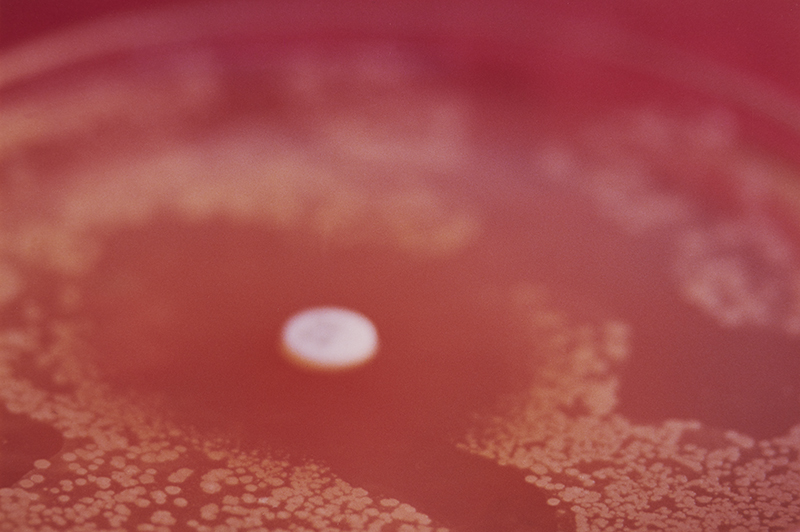
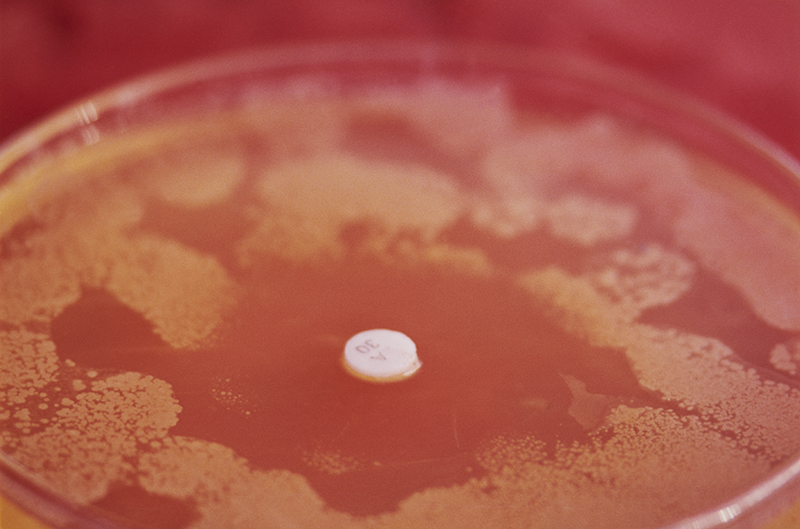

BESARA MI LENGUA
[growing bacteria from artist’s saliva in Petri dishes + landscape gardening]
[photographs of bacterial cultures from the artist's saliva on Petri dishes]

3

1. Jardín Húmedo, 1997; photograph, 70 x 105 cm
2. Ese Jardín Que Es Suyo, 1997; photograph, 92 x 138 cm
3. Aliento Mi Jardín, 1997; photograph, 70 x 105 cm
4. Jardín Simétrico, 1997; photograph, 92 x 138 cm
5. Vengo Jardín, 1997; photograph, 92 x 138 cm
2. Ese Jardín Que Es Suyo, 1997; photograph, 92 x 138 cm
3. Aliento Mi Jardín, 1997; photograph, 70 x 105 cm
4. Jardín Simétrico, 1997; photograph, 92 x 138 cm
5. Vengo Jardín, 1997; photograph, 92 x 138 cm